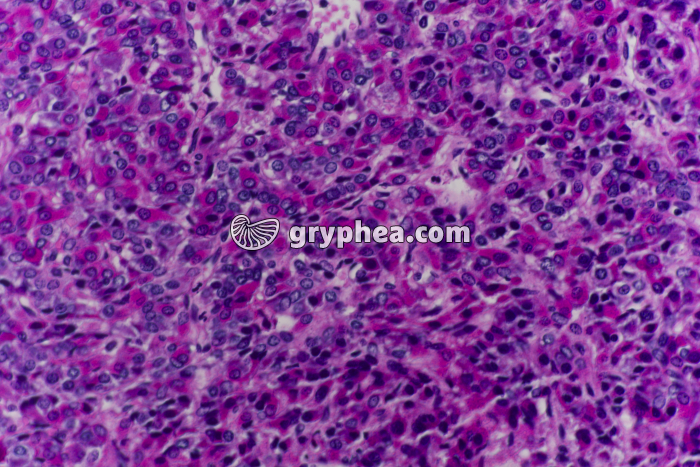
Hypophyse antérieure x100 - gryphea.com

Type : Photographie
Référence : BN 52457
Auteur : Hervé Conge
Edition et PresseNumérique et Internet
Valeur du crédit
1 crédit = 6.00€ TTC
(Hors pack)
1 crédit = 6.00€ TTC
(Hors pack)
si vous êtes enseignant, le site gryphea.org a été conçu spécialement pour vous !
Edition et Presse
Paramètres additionnels
Tirage
Distribution
Durée d'utilisation
Droits numériques en sus
Total : crédits
Ajouter au panier
Numérique et Internet
Paramètres additionnels
Numérique
Internet
Durée d'utilisation
Total : crédits
Ajouter au panier
Numérique et Internet
Paramètres additionnels
Numérique
Internet
Durée d'utilisation
Total : 4 crédits
Ajouter au panier
Légende :
La suite du commentaire est réservée aux inscrits, créez un compte gratuitement.
L’hypophyse est une petite glande située à la base du cerveau chez les Vertébrés, responsable de la synthèse et de la sécrétion de plusieurs hormones influant sur l’activité métabolique et hormonales d’autres organes du corps.
Elle dépend elle-même des sécrétions de neuro-hormones produites par une autre partie du cerveau, située juste à proximité, l’hypothalamus.
...La suite du commentaire est réservée aux inscrits, créez un compte gratuitement.
Thèmes associés :
Système endocrinien